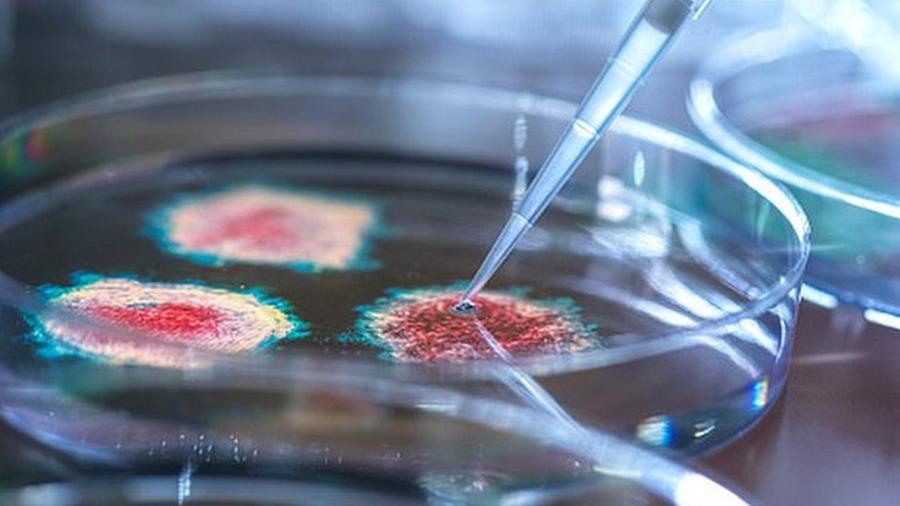

Мир
Любителей жевательной резинки предупредили о рисках для пищеварения.
USD 71,2090 EUR 82,5445

Мир
Любителей жевательной резинки предупредили о рисках для пищеварения.

Россия
МИД РФ сообщил о начале системных ударов по объектам ВПК в Киеве

СКФО
Сбер компенсировал предпринимателям Северного Кавказа более 3,5 млн рублей НДС за эквайринг

Блоги
В Госдуме отреагировали на рождественское обращение Зеленского с пожеланием смерти
Главная » НОВОСТИ » Японские ученые обнаружили новую мутацию COVID-19
14.01.2021 09:57
Японские ученые из Национального института инфекционных заболеваний обнаружили в анализах четырех туристов из Бразилии признаки новой разновидности коронавируса Sars-Cov-2. Об этом сообщает Русская служба BBC.
По словам экспертов, вирус снова мутировал — причем несколько изменений вновь произошли на участке генома, отвечающем за форму шиповидного белка, при помощи которого вирусные частицы проникают в наши клетки. Предварительный генетический анализ показал наличие в РНК привезенного из штата Амазонас вируса полтора десятка мутаций. По меньшей мере три из них встречались ученым и раньше — в том числе та, что печально известна под кодовым названием N501Y (замена аминокислоты аспарагин на тирозин в 501-й позиции спайк-белка). Ровно такая же мутация ранее была обнаружена у пациентов в Великобритании и Южной Африке.
Мария ван Керкхове, отвечающая в ВОЗ за борьбу с пандемией Covid-19, призвала власти всех стран к бдительности, так как новая мутация, которую ученые между собой уже называют «бразильским штаммом», скорее всего, также трудно поддается сдерживанию. Особые опасения у экспертов вызывает тот факт, что изменения на этом участке генома, кажется, не связаны между собой — то есть во всех трех случаях (в Британии, Бразилии и ЮАР) одна и та же мутация произошла независимо. Есть у «бразильской» разновидности вируса и еще одна опасная мутация — E484K.
Напомним, в Великобритании в конце 2020 г. была обнаружена новая мутация коронавируса, которая, по словам ученых, является более заразной.
Все права защищены. При перепечатке ссылка на сайт ИА "Грозный-информ" обязательна.
Нашли ошибку в тексте? Выделите ее мышкой и нажмите: Ctrl+Enter
Поделиться: